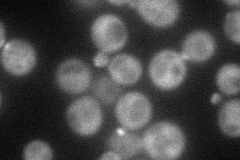
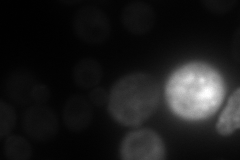
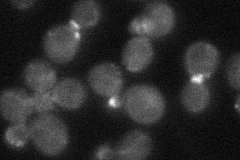
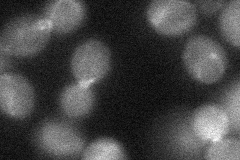
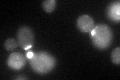

View description
Essential 100kDa subunit of the exocyst complex (Sec3p, Sec5p, Sec6p, Sec8p, Sec10p, Sec15p, Exo70p, and Exo84p), which has the essential function of mediating polarized targeting of secretory vesicles to active sites of exocytosis
Localization:
Intensity:
Fold change:
Significance:
-
C’ GFP library in SD

bud neck -
N' NOP1pr-GFP in SD
cytosol,bud71.7945 -
N' TEF2pr-mCherry in SD
bud neck46.1236 -
N' NATIVEpr-GFP in SD
punctate,bud neck28.8989 -
N' TEF2pr-VC and Cyto-VN in SD
bud neck30.4662 -
C’ GFP library in SD+DTT
bud neck31.681.03No -
C’ GFP library in SD+H2O2

cytosolN/AN/ANo -
C’ GFP library in Starvation Media

punctateN/AN/AYes -
C’ GFP library on the background of Pup2-DaMP

bud neck -
C’ GFP library on the background of CCT mutant

bud neck27.14260.888572No
